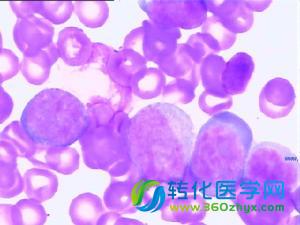
医药生物行业:遇上最好的时代,肿瘤免疫治疗

又一款图像类移动医疗APP获FDA批准
FDA已通过了Visage Imaging旗下Visage Ease Pro的iOS应用的510(k)申请。(注:产品上市前向FDA提交证明,表明在市场上销售的安全性和有效性,该申请即510(k),实质上相当于获得合法效销售的资格),除了乳房X线照片,这款移动诊断APP能翻译绝大多数的影像信息。
走访红房子集爱遗传与不育诊疗中心 “升级版”三
今年2月,上海市红房子妇产科医院(即复旦大学妇产科医院)集爱遗传与不育诊疗中心成功诞生胚胎植入前经全基因组筛查的健康宝宝。
上周生物医药领域五大新闻
辉瑞收购阿斯利康失败一周年记 辉瑞放弃收购阿斯利康事件已过去一年,英国药品制造商们由此意识到,收购强大的研发线对于生产新药是多么重要。虽然这次收购存在争议――辉瑞这么做是为了借机降低公司税率,这次收购仍为英国药品制造商们提供绘制了一幅快速生产线蓝图;到2023年,顶级生产线可创造出450亿美元的利润。 由于担心牛皮癣治疗药物brodalumab药物增加患...
欧洲生物科技一周报告
1、强生公司在卡罗林斯卡学院建立创新基地 强生已经在卡罗林斯卡学院(一所瑞典医学院)建立基地,旨在保持公司研究不断取得突破,推动最前沿生命科学的起步。 2、礼来、Zealand终止糖尿病药物研发合作 礼来、Zealand Pharma糖尿病药物合作终止。两家公司2013年建立合作,共同研发新的多肽药物,用于治疗II型糖尿。21个月后,研究并未...
制药巨头合力之下,抗乳腺癌药物2020年销售额
根据Bloomberg Intelligence报告,抗乳腺癌品牌药物2014年销售额为130亿美元,预计2020年这个数字将上涨至200亿。
一位美国医学信息学博士生眼中的中美医疗信息化差
张少典是美国哥伦比亚大学医学信息学系(美国最顶尖的医学信息学系之一)的5年级博士生,主攻医学自然语言处理和数据挖掘方向。很快就将面临毕业的他近日回到了国内,计划用一个月的时间考察学习中国的医疗信息化现状。在参观间隙,他接受了健康界的采访。
2015,福布斯亿万富豪榜的13位医药大佬
每年福布斯都会发布全球亿万富豪榜单,记录着全球富豪的资产,医药行业也不例外。今年3月初,福布斯发布的新榜单中共有30位医药业大佬入选。
人民日报眼中的“互联网+医疗”
“互联网+医疗”不是简单的“医疗+互联网”,它利用互联网特点,开拓了新的经济形态,在医药服务的细分领域对其存量和增量进行创新。
瑞典卡罗林斯卡医学院教授因学术不端被调查
5月27号,经过一系列调查后,瑞典卡罗林斯卡医学院(Karolinska Institute)公布关于对外科医生Paolo Macchiarini的调查报告,报告称Macchiarini存在学术不端的行为。
食药监总局医疗器械监管司长童敏被调查 器械药品
童敏,男,汉族,1963年1月出生,江西南昌人,1992年12月加入中国共产党,1986年7月参加工作,北京轻工学院计算机及应用专业毕业,大学本科学历。
美国医改5周年:5个维度盘点谁是赢家输家
五年前,奥巴马总统签署了《患者保护与平价医疗法案》。从那以后,医疗卫生领域出现了很多改变。该法案按照其基本目标平稳地降低了美国未享受医疗保险人群的比例。2015年,美国未享受医疗保险成年人的比例仅为12.9%。而在该法案获得通过的2010年,这一数字为16.4%。
制药巨头合力之下,抗乳腺癌药物2020年销售额
根据Bloomberg Intelligence报告,抗乳腺癌品牌药物2014年销售额为130亿美元,预计2020年这个数字将上涨至200亿。
精准医疗进入发展快轨 肿瘤检测市场先行
造血干细胞移植、基因芯片诊断、免疫细胞治疗等第三类医疗技术临床应用准入审批日前取消。在此之前,国家卫计委、科技部等多次出台政策,并组织生物医药等领域专家对精准医疗、基因测序等开展研究。
深圳布局脑科学前沿研究领域—“孔雀团队”新兴遗
记者从5月23日举办的中科院深圳先进技术研究院―MIT麦戈文联合脑认知与脑疾病研究所学术研讨会获悉,深圳市海外高层次人才“孔雀计划”引进的“新兴遗传工程介导重大脑疾病研究创新团队”项目正式启动,这是深圳在脑科学这一国际前沿领域实现的重要布局。
栏目推荐
| 第五届单细胞技术应 |
| 【快讯】翌圣生物完 |
 腾讯登录
腾讯登录